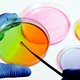
Microbiologico 800x500

-
Almudena Díaz Pereira, Mejoramiento genético de la levadura Phaffia rhodozyma para una mayor producción de el pigmento astaxantina, un carotenoide utilizado para aliviar los síntomas de la inflamación.
-
Quinteros Borgarello, Milva; Delgado Molina, Esther; Sánchez Garcés, Mª Ángeles; Berini Aytés, Leonardo; Gay Escoda, Realizaron un experimento para determinar qué bacterias se encontraban en mayor instancia en casos de periimplantitis siendo Stomatococcus la mas dominante durante la investigación.
-
C. Rubio Quevedo, M.aA.Holgado Carballo A.García SuárezI.Martín de LaraL.Moltó Ripoll. realizaron un estudio para conocer la tasa de transmisión vertical de la hepatitis.
-
Dr. Carlos L González Correa, comprobó la susceptibilidad de Helicobacter pylory a ciertos medicamentos (amoxicilina Metronidazol, Subcitrato de bismuto), así como la presencia de cepas resistentes a claritromicina en chile siendo las primeras cepas aisladas en la región.
-
C. Aspiroz Sancho, A. Agustín Berne, C. Navarro Pardos, B. Sañudo Blasco*, P. Teller Justes, describen un caso clínico en el cual la bacteria gram-positiva Corynebacterium pseudodiphteriticum, es el agente causal de la enfermedad.
-
Gallardo F, Plaza JC, De la Sotta R. Estudian los efectos que de un gel de tetraciclina al 5% sobre los niveles de 3 microorganismos asociados al desarrollo de la periodontitis rápidamente progresiva (PRP). En un total de 20 pacientes con PRP.
-
Gary Nabel (Vaccine Research Center, National Institute of Allergy and Infectious Diseases, National Institutes of Health) crean vacuna contra el ébola, una sola dosis para monos.
-
Joe DeRisi crea el ViroChip e identifica qué tipo de virus causa la SARS de este año.
-
La Gilead Sciences de California, lanza combinación Truvada (tenovir y emtricitabine) para tratar el SIDA.
-
Ciechanover (Biólogo), Hershko (Biólogo) y Rose descubren el mecanismo por el cual las células se deshacen de las proteínas en los proteasomas y ganan Premio Nobel.
-
Marshall y Warren ganan el premio Nobel por descubrir que Helicobacter pylori causa úlceras pépticas.
-
Científicos del Centers for Disease Control and Prevention (CDC) reconstruyen replica del virus de la gripa española de 1918
-
Roger David Kornberg. Premio Nobel de Química 2006, por dilucidar la estructura tridimensional del complejo enzimático ARN polimerasa II de la levadura.
-
Andrew Zachary Fire. descubrimiento de la interferencia ARN. es una molécula de ARN que suprime la expresión de genes específicos mediante mecanismos conocidos globalmente como ribointerferencia o interferencia por ARN.
-
Mario Capecchi. células madre y manipulación genética en modelos animales, técnica de gene targeting. técnica que se sirve de la recombinación homóloga para modificar un gen utilizada en microorganismos.
-
Dr. Magdi Yacoub lograron hacer crecer células madre de médula ósea hasta convertirse en tejido cardíaco. Esperan que ese tejido pueda luego crecer para formar una válvula del corazón.
-
Osamu Shimomura. descubrimiento y desarrollo de la proteína verde fluorescente (GFP). Actualmente se utiliza en biología molecular como marcador.
-
Harald zur Hausen. descubrió el papel del virus del papiloma humano.
-
Dong Guo, Ying Zhou, Hui-Liang Li, Jia-Hong Zhu, Ying Wang, Xiong-Ting Chen & Shi-Qing Peng. El descubrimiento en las células de las plantas de receptores para el ácido abscísico, un compuesto químico que permite a las semillas permanecer latentes y que impide que las plantas pierdan agua durante los períodos de sequía. Explotar ese hallazgo podría mejorar las producciones de cosechas en tierras consideradas hasta ahora demasiado secas.
-
Científicos del MIT desarrollaron un prototipo de batería de ión de litio cuyo cátodo y ánodo han sido fabricados con virus genéticamente modificados. Podría alcanzar una capacidad y un rendimiento energéticos similares a los de las actuales baterías recargables de los vehículos eléctricos híbridos.
-
John Craig Venter creó la primera célula sintética. Se trata de un híbrido que posee la estructura natural de una bacteria natural pero con material genético artificial. Para ello, desarrolló un cromosoma sintético, réplica del genoma de la bacteria Mycoplasma myoides, y lo transplantó a otra bacteria viva que actuó como recipiente para el nuevo ser.
-
Daniel G. Gibson. Creación de una célula bacteriana con genoma sintetizado químicamente.
-
- Jean Michel Claverie. Se descubre el virus más grande conocido hasta ese año. El Megavirus chilensis es un virus de ADN, pariente lejano del grupo Mimivirus, que infecta a las Acanthamoeba. Fue descubierto por científicos franceses en el mar chileno, en la costa de Chile. Tiene un tamaño 20 veces superior al normal: 700 nm.
-
Emil Kazarov. Un equipo de expertos identificó bacterias específicas que podrían tener un papel clave en la aterosclerosis, o lo que comúnmente se describe como "endurecimiento de las arterias", y que está causado por la formación de una placa dura, que puede conducir a ataques al corazón y derrames cerebrales.
-
El Consejo Superior de Investigaciones Científicas logra describir comportamiento de la proteina FTSZ implicada en la division celular microbiana.
-
Investigadores de los laboratorios de la compañía española Ordesa obtienen cepa probiótica que actúa contra infecciones de rotavirus.
-
Un grupo de investigadores de la Estación Experimental de Zidin perteneciente al CSIC descifran el genoma completo de la bacteria que fija el nitrógeno atmosférico.
-
Científicos de la Universidad de Carolina del Norte en colaboración con la Universidad de Colorado, demuestran cómo el virus de la hepatitis sobrevive en el hígado.
-
Sheik Humarr Khan. consiguió los primeros estudios de secuencia genética del virus del ébola en pleno brote de este.
-
Un equipo de científicos del Instituto de Investigación Scripps (EEUU) logró este año el diseño de una bacteria (E.coli) semisintética que contiene material genético extra, esto es, un nuevo tipo de ADN sin base en la naturaleza. Esta bacteria, creada en laboratorio, contiene dos ácidos nucleicos adicionales (X e Y). La posibilidad de añadir nuevas letras al ADN abre la puerta a la producción de bacterias artificiales capaces de sintetizar medicinas o incluso de fabricar combustibles.
-
Tu Youyou recibe la mitad del premio nobel en medicina por su trabajo respecto al descubrimiento y aislamiento de la artemisinina, utilizada para tratar la malaria.
-
William C. Campbell y Satoshi Oumura obtienen la segunda mitad del premio Nobel en medicina por aislar la avermectina desde una bacteria y, a partir de esta, sintetizar ivermectina, la cual es usada para tratar diferentes enfermedades parasitarias causadas por nemátodos.
-
Filipinas lanza el primer programa público de inmunización contra la fiebre del dengue, buscando administrar la primer vacuna aprobada para esta enfermedad.
-
El CDC de los Estados Unidos anuncia que el virus del Zika causa que los bebés nazcan con cabezas anormalmente pequeñas y/u otros defectos cerebrales severos.
-
Científicos Alemanes del Instituto Robert Koch identifican y aíslan una nueva especie de virus de la familia Poxviridae.
-
Jaques Dubochet, Joachim Frank y Richard Henderson desarrollo de la microscopía electrónica para fotografiar moléculas tridimensionalmente. Premio Nobel 2017.
Want to make a timeline like this?
Use Timetoast to turn dates, events, milestones, and phases into a clear visual timeline you can build and share. Timetoast is a timeline maker for work, school, research, and stories.